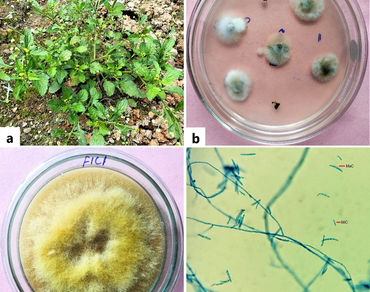
Biological activities and GC-MS analysis of crude extract of an endophytic fungus Fusarium sp. F1C1

Vol 37 Issue 5, October 2024
Total Articles: 48

Moringa oleifera: its industrial and pharmaceutical applications. A review
Review Articles
Views: 5249
Pages: 1679-1689
Published: 14 March, 2024
Doi: 10.1007/s42535-024-00866-8

Morphology, chemical composition, and biological activities of Aconitum balfourii: a comprehensive review of important Himalayan and highly exploited medicinal plant
Review Articles
Views: 3439
Pages: 1690-1704
Published: 02 August, 2024
Doi: 10.1007/s42535-024-00995-0

Effect of essential plant nutrients on growth and yield of maize crop (Zea mays L.): a review
Review Articles
Views: 3263
Pages: 1705-1719
Published: 26 September, 2024
Doi: 10.1007/s42535-024-01024-w
Biological activities and GC-MS analysis of crude extract of an endophytic fungus Fusarium sp. F1C1
Research Articles
Views: 3427
Pages: 1720-1732
Published: 12 February, 2024
Doi: 10.1007/s42535-024-00817-3

The structural and performance characterization of bamboo fibers treated with calcium hydroxide solution
Research Articles
Views: 3482
Pages: 1733-1740
Published: 08 February, 2024
Doi: 10.1007/s42535-023-00807-x

In vitro propagation and assessment of genetic fidelity of Blepharispermum subsessile DC.: an endangered medicinal plant of India
Research Articles
Views: 3906
Pages: 1741-1750
Published: 30 March, 2024
Doi: 10.1007/s42535-024-00851-1

Effect of Biofabricated Silver nanoparticles on Growth parameters in Fenugreek (Trigonella foenum-graecum)
Research Articles
Views: 3565
Pages: 1751-1759
Published: 12 April, 2024
Doi: 10.1007/s42535-024-00878-4

Current status of tree species diversity at Abu Gadaf Natural Forest Reserve, Blue Nile Region – Sudan
Research Articles
Views: 3438
Pages: 1760-1771
Published: 31 May, 2024
Doi: 10.1007/s42535-024-00931-2

Effect of fallow period on soil seed bank runoff and regeneration of successional forests
Research Articles
Views: 3240
Pages: 1772-1780
Published: 07 June, 2024
Doi: 10.1007/s42535-024-00945-w